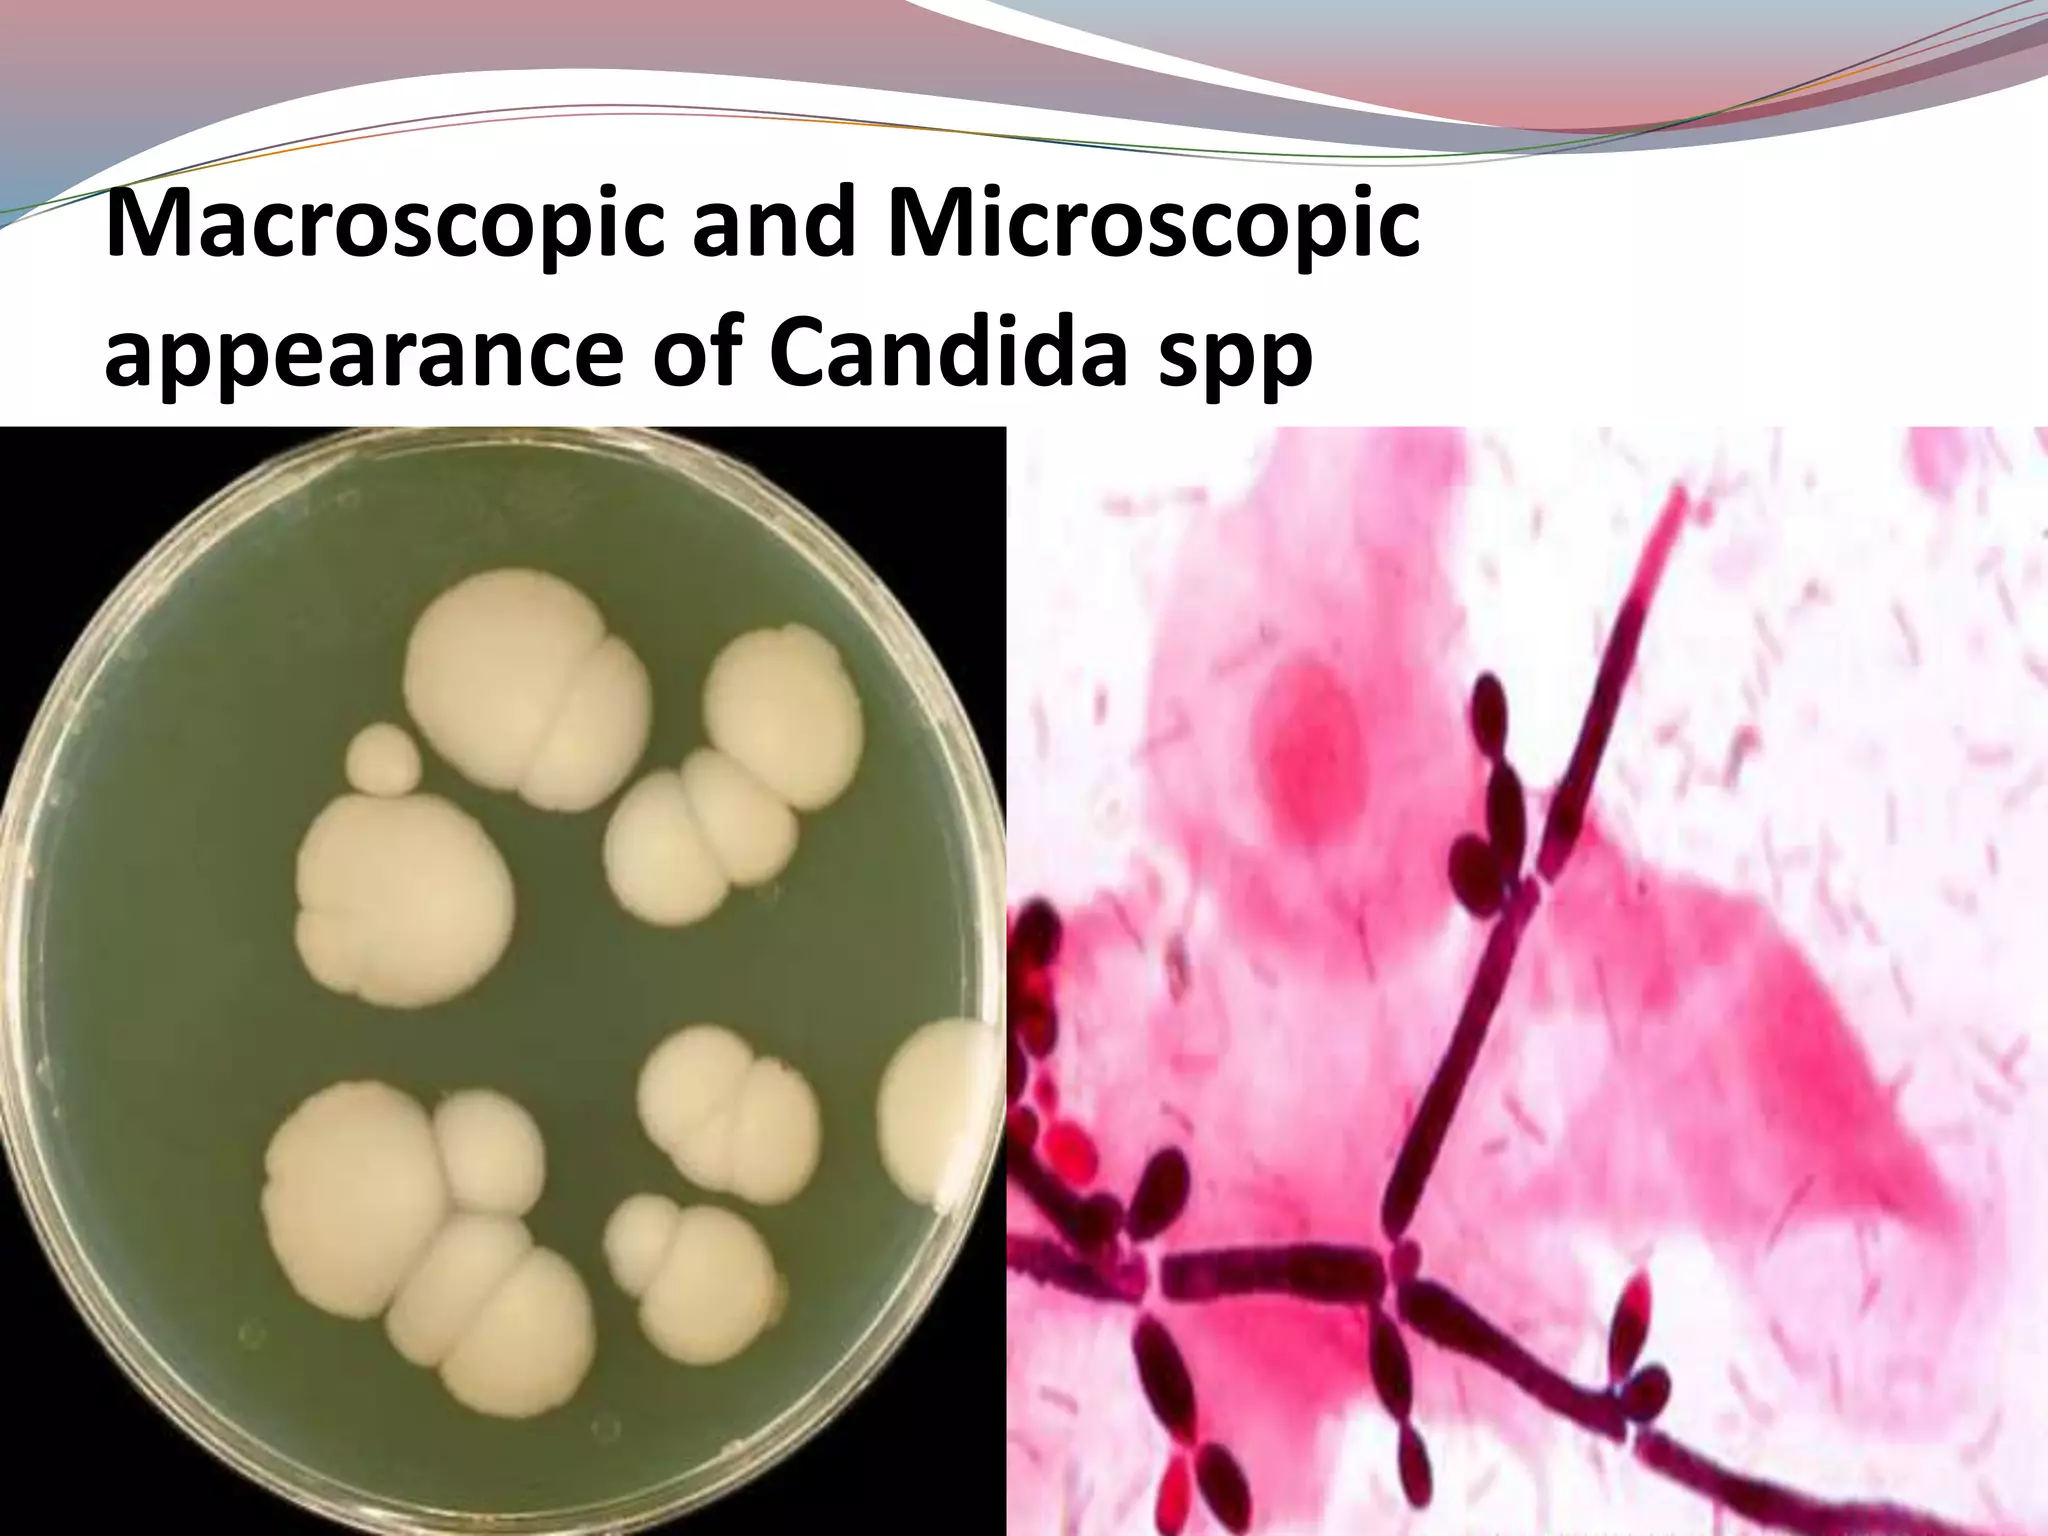
Macroscopic and Microscopic
appearance of Candida spp

Candidiasis, also known as candidosis or thrush, is an infection caused by the yeast-like fungus Candida, with Candida albicans being the most common species. It can present in various forms including acute and chronic candidiasis, systemic candidiasis, and mucocutaneous candidiasis, often affecting immunocompromised individuals and presenting symptoms like white plaques in the oral cavity. Diagnosis typically involves culture and staining techniques, with treatment options including antifungal medications and improving oral hygiene.